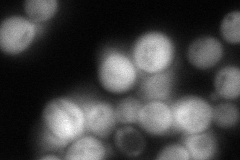
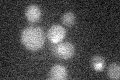

View description
Polyamine acetyltransferase; acetylates polyamines (e.g. putrescine, spermidine, spermine) and also aralkylamines (e.g. tryptamine, phenylethylamine); may be involved in transcription and/or DNA replication
Localization:
Intensity:
Fold change:
Significance:
-
C’ GFP library in SD

below threshold15.05 -
N' NOP1pr-GFP in SD

cytosol270.121 -
N' TEF2pr-mCherry in SD

cytosol497.656 -
N' NATIVEpr-GFP in SD
punctate117.905 -
N' TEF2pr-VC and Cyto-VN in SD

cytosol80.1678 -
C’ GFP library in SD+DTT

cytosol14.440.95No -
C’ GFP library in SD+H2O2

cytosol16.51.09No -
C’ GFP library in Starvation Media
cytosol17.761.17No -
C’ GFP library on the background of Pup2-DaMP

N/A -
C’ GFP library on the background of CCT mutant

N/A0N/AYes
